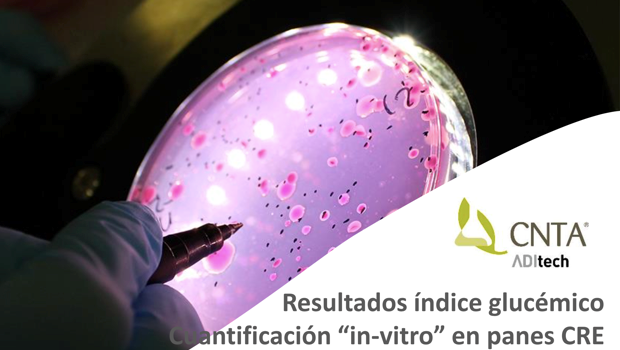
glucemico

Proyectos
Estos primeros estudios in vitro parece señalar que a mayor MMC y reposos largos se da un descenso en los valores de IG predicho in vitro. ¿Qué es el índice glucémico? Es una medida del incremento de la glucosa en sangre tras la ingestión de un alimento. Los alimentos se clasifican de acuerdo a su índice glucémico porcomparación con un control: Gl...
El CRE realiza frecuentes actividades. Adjuntamos los informes de las principales actividades realizadas en los ejercicios. Objetivo del estudio De acuerdo al presupuesto aceptado por la empresa CRE (PE20151342) se planteó como el objetivo del estudio, la "caracterización microbiológica y química de las masas madres de cultivo (MMC) de las em...
Legal
Club Richemont España
Avda. de Madrid s/n
CETECE
La Yutera 34004 Palencia